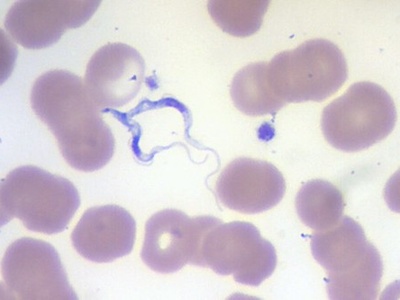
African trypanosome

Parasitism touches every corner of life — from tropical forests and coral reefs to farms and the human body. These interactions, often hidden, shape behavior, population dynamics, and disease cycles in ways that matter to ecology and public health.
There are 20 Examples of Parasitism, ranging from African trypanosome to Zombie-ant fungus. The list highlights different hosts and strategies; for each entry you’ll find below the Scientific name, Hosts, Parasitism type so you can quickly compare lifecycles, transmission, and impact on hosts.
Are any of these parasites dangerous to humans?
Yes — some on the list (for example African trypanosome) cause serious human disease, while others primarily affect wildlife, plants, or insects. Risk depends on the species, how it’s transmitted, and local exposure; treatment and prevention vary accordingly, so check the specific entry below for control measures and human health relevance.
How should I use the Scientific name, Hosts, Parasitism type columns?
Use the Scientific name to avoid ambiguity, the Hosts column to see which organisms are affected, and the Parasitism type to understand the interaction (e.g., ectoparasite, endoparasite, parasitoid). Together they let you sort for host range, ecosystem role, or medical importance in the entries you’ll find below.
Examples of Parasitism
| Name | Scientific name | Hosts | Parasitism type |
|---|---|---|---|
| Malaria parasite | Plasmodium falciparum | Humans (vertebrate), Anopheles mosquitoes (vector) | Endo; obligate |
| Toxoplasma | Toxoplasma gondii | Cats (definitive), many mammals and birds including humans | Endo; obligate |
| Blood fluke | Schistosoma mansoni | Humans (definitive), freshwater snails (intermediate) | Endo; obligate |
| African trypanosome | Trypanosoma brucei | Humans, livestock; tsetse flies (vector) | Endo; obligate |
| Pork tapeworm | Taenia solium | Humans (definitive), pigs (intermediate); humans can be accidental intermediate hosts | Endo; obligate |
| Human roundworm | Ascaris lumbricoides | Humans | Endo; obligate |
| Honey bee mite | Varroa destructor | Honey bees (Apis mellifera) | Ecto; obligate |
| Blacklegged tick | Ixodes scapularis | Deer, rodents, humans, other mammals | Ecto; obligate |
| Head louse | Pediculus humanus capitis | Humans (scalp) | Ecto; obligate |
| Oriental rat flea | Xenopsylla cheopis | Rats, humans, other mammals | Ecto; obligate |
| Zombie-ant fungus | Ophiocordyceps unilateralis | Carpenter ants (Camponotus spp.) | Parasitoid; obligate |
| Dodder | Cuscuta campestris | Many herbaceous plants and crops | Endo; obligate |
| Corpse flower parasite | Rafflesia arnoldii | Tetrastigma vines (host vine) | Endo; obligate |
| Parasitic barnacle | Sacculina carcini | Shore crabs (Carcinus maenas) | Endo; obligate |
| Braconid wasp | Cotesia congregata | Tobacco hornworm caterpillars and related moth larvae | Parasitoid; obligate |
| Common cuckoo | Cuculus canorus | Many small songbirds (reed warblers, etc.) | Brood; obligate |
| Root-knot nematode | Meloidogyne incognita | Wide range of crop plants | Endo; obligate |
| Wheat stem rust | Puccinia graminis | Cereals, especially wheat and barley | Endo; obligate |
| Human immunodeficiency virus | Human immunodeficiency virus (HIV) | Humans | Endo; obligate |
| Leprosy bacterium | Mycobacterium leprae | Humans, armadillos in some regions | Endo; obligate (intracellular) |
Images and Descriptions

Malaria parasite
Single-celled protozoan causing the most lethal form of human malaria, found mainly in tropical regions; invades red blood cells, causes fever and anemia, and relies on mosquitoes to complete its life cycle.

Toxoplasma
A widespread protozoan that completes sexual reproduction in cats but infects most warm-blooded animals; often mild in people but can harm fetuses and alter rodent behaviour to aid transmission.

Blood fluke
A flatworm causing intestinal schistosomiasis in tropical freshwater zones; larvae penetrate skin, live in blood vessels, cause chronic organ damage and rely on snails to develop.
African trypanosome
Protozoan causing sleeping sickness in Africa; lives in blood and tissues, transmitted by tsetse flies, leading to fever, neurological decline, and often death if untreated.

Pork tapeworm
A large intestinal tapeworm acquired by eating undercooked pork; larval cysts in human tissues can cause neurocysticercosis, a serious cause of seizures worldwide.

Human roundworm
One of the most common human intestinal worms globally; eggs spread in soil, larvae migrate through lungs then mature in intestines, causing malnutrition and sometimes intestinal blockage.

Honey bee mite
Tiny parasitic mite that infests honey bee colonies worldwide, feeding on bee blood (hemolymph), spreading viruses, and contributing to colony collapse if unmanaged.

Blacklegged tick
Hard tick that transmits Lyme disease and other pathogens in North America; attaches for days to feed on blood, transferring bacteria and viruses between hosts.

Head louse
A tiny, human-specific insect that lives and lays eggs on hair shafts; causes itching and social concern but isn’t a major disease vector.

Oriental rat flea
A flea that infests rodents and occasionally humans; historically notable as the primary vector for Yersinia pestis (plague) and other flea-borne infections.

Zombie-ant fungus
A tropical fungus that infects ants, manipulates behaviour to bite vegetation, then kills the host to grow a spore-producing stalk—an extreme example of host control.

Dodder
Leafless vine that wraps hosts with twining stems, inserting haustoria to steal water and nutrients; can devastate gardens and agricultural fields.

Corpse flower parasite
The world’s largest single flower is actually a rootless, leafless parasitic plant that lives entirely inside a vine and emerges briefly to bloom with a strong carrion smell attracting pollinators.

Parasitic barnacle
A crustacean that injects root-like tissue into a crab’s body, hijacks its hormones, and externally produces reproductive bodies while castrating and controlling the host.

Braconid wasp
Small wasp that lays many eggs inside caterpillars; larvae develop internally then emerge to pupate, typically killing the host—used in biological control research.

Common cuckoo
A brood-parasitic bird that lays eggs in other species’ nests; cuckoo chicks often outcompete or eject host young, tricking foster parents into raising them.

Root-knot nematode
Microscopic roundworm that invades plant roots causing galls or “knots,” reducing water uptake and crop yields worldwide; major agricultural pest managed with crop rotation and resistant varieties.

Wheat stem rust
A rust fungus that parasitizes cereal crops, causing reddish pustules that reduce yield; historically caused famines and still threatens food security without resistant varieties.

Human immunodeficiency virus
A retrovirus that infects immune cells, weakening host defenses and causing AIDS if untreated; transmitted via blood, sex, and from mother to child; global public-health challenge.

Leprosy bacterium
Slow-growing bacterium causing leprosy (Hansen’s disease); infects skin and nerves, leading to disfigurement and disability if untreated—transmission and reservoirs include armadillos in the Americas.









